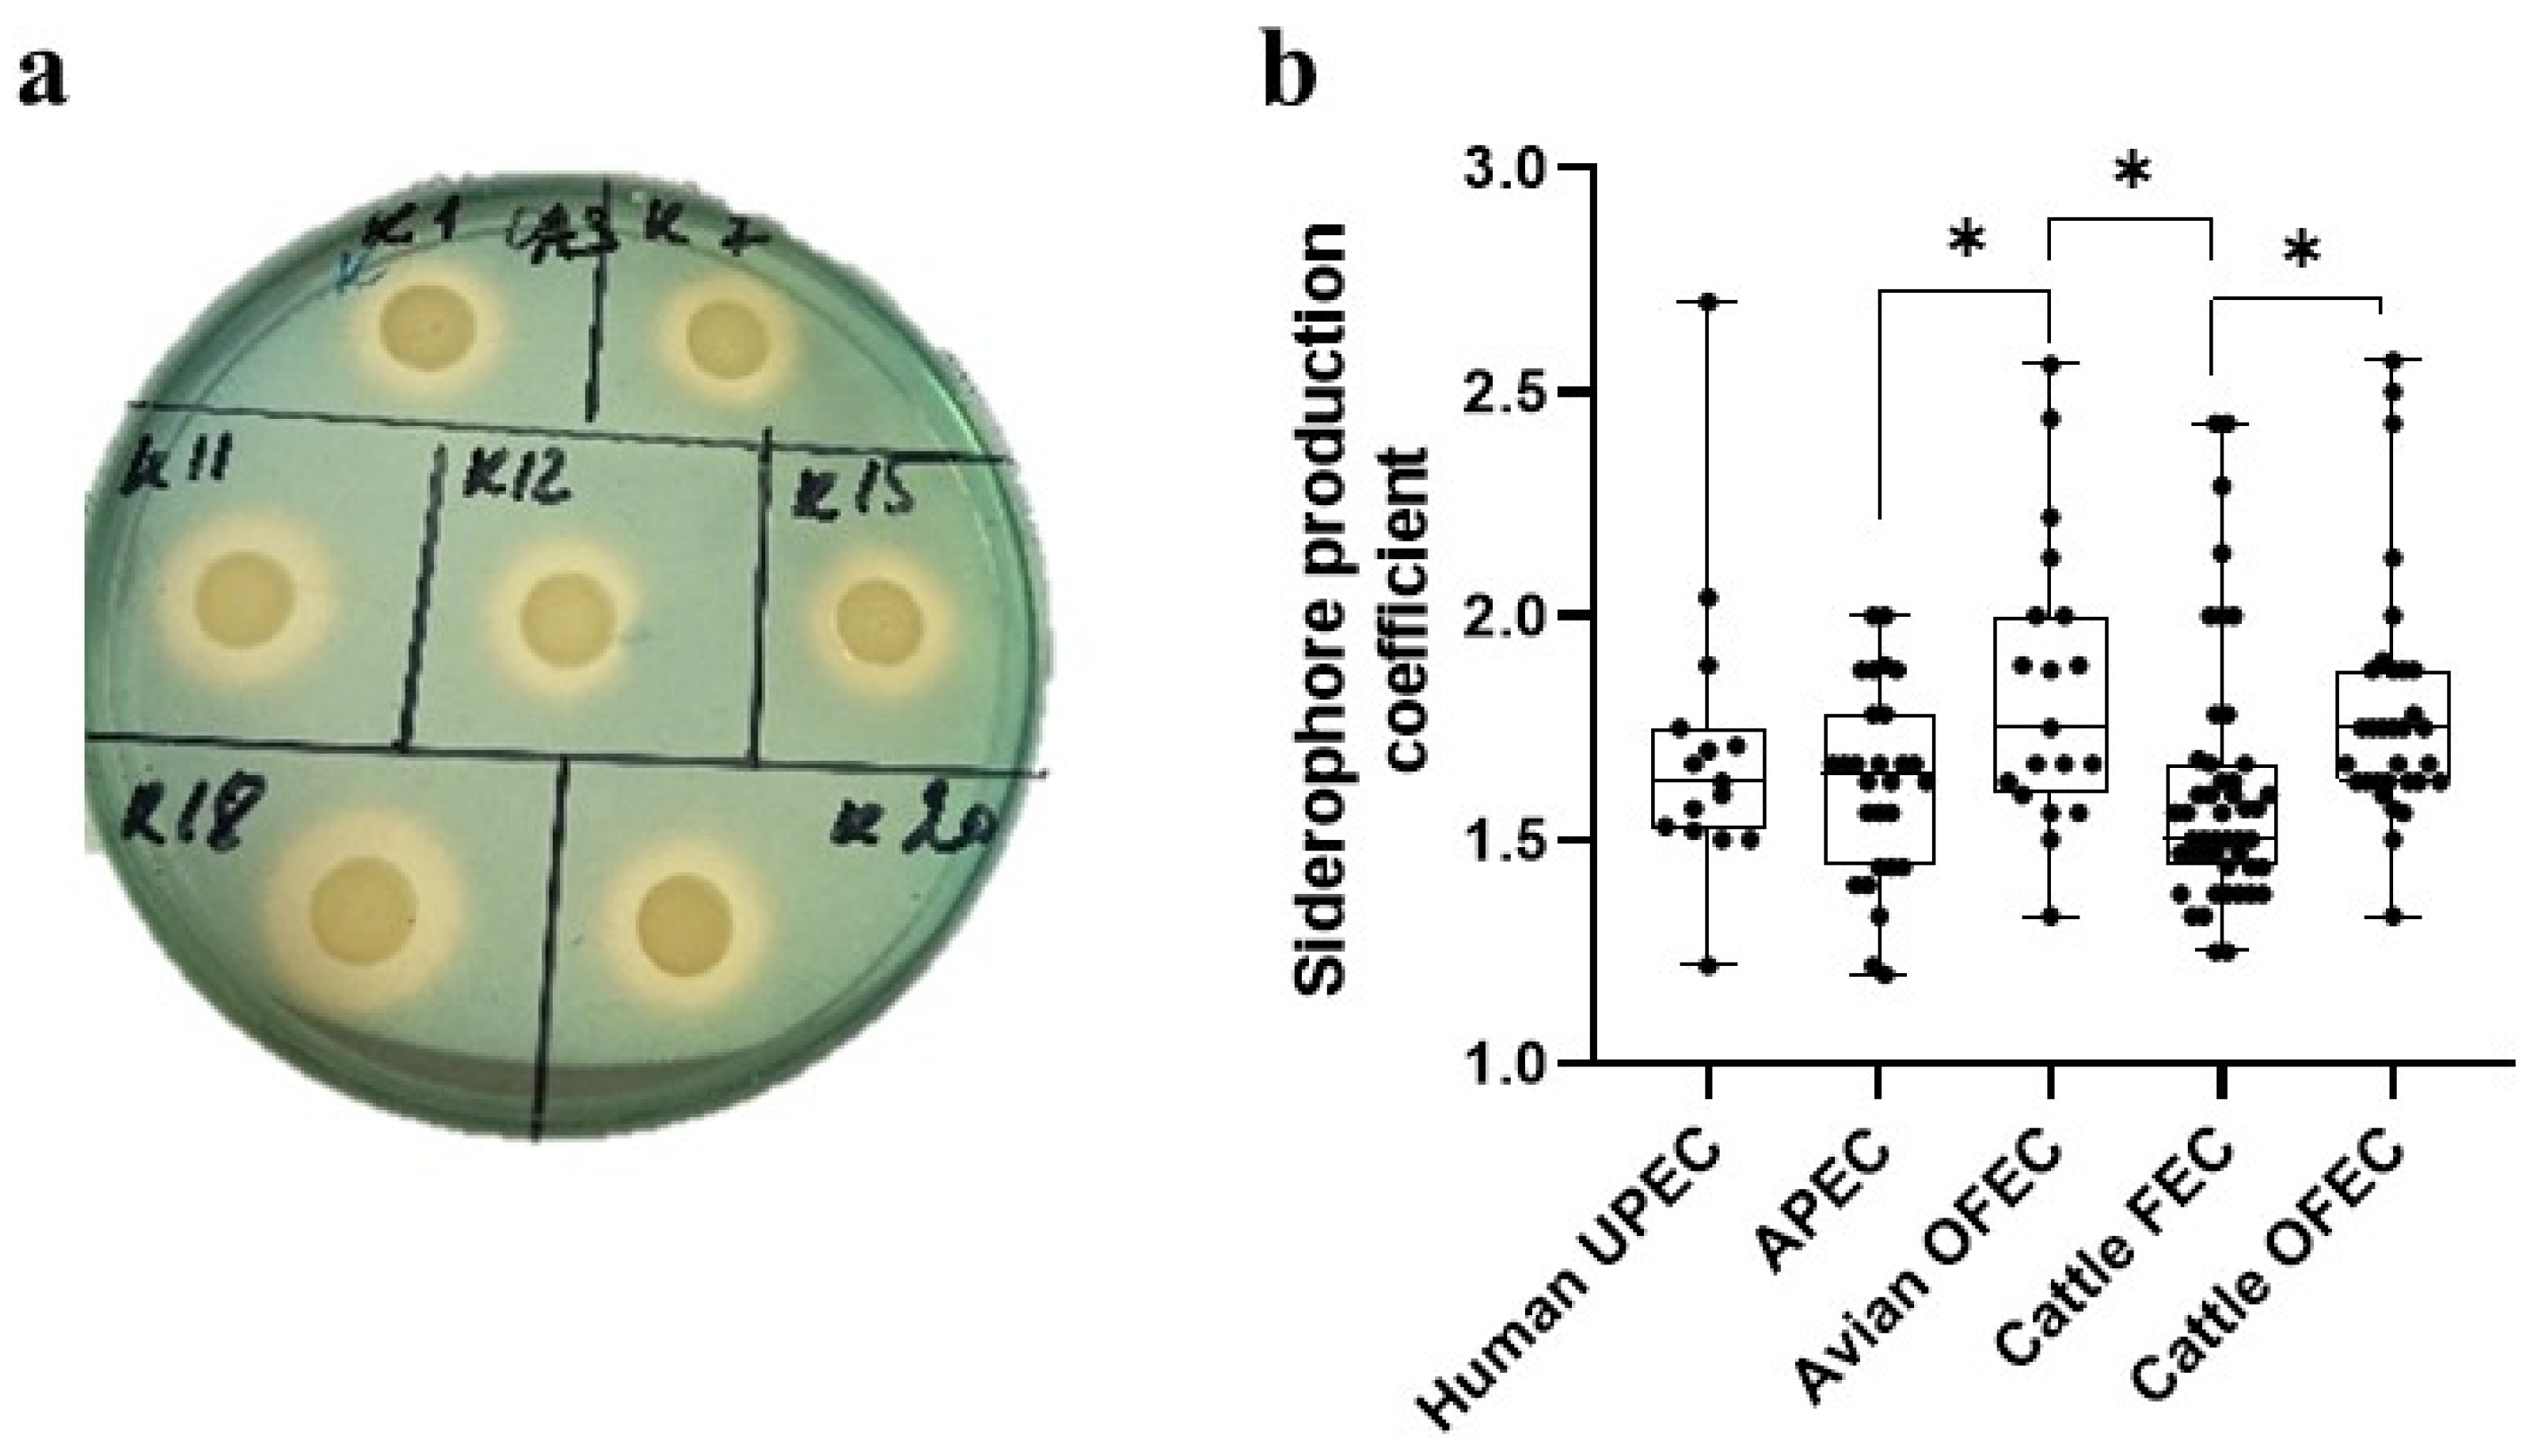
Microbiolres 16 00050 g001 Microbiolres 16 00050 g001

Siderophore Production, Diversity of Siderophore Receptors and Associations with Virulence-Associated Genes, Phylogroups and Bacteriocin Production in Escherichia coli Strains Isolated from Humans, Animals and Organic Fertilizers
Abstract
1. Introduction
2. Materials and Methods
2.1. Bacterial Strains
2.2. Iron Uptake Test
2.3. DNA Extraction
2.4. Detection of Genes Encoding Siderophore Receptors and Microcins
2.5. Detection of Virulence-Associated Genes and Phylogroups
2.6. Bacteriocin Production
2.7. Statistical Analysis
3. Results
3.1. Comparison of Siderophore Production and Diversity in E. coli Populations
3.1.1. Siderophore Production
3.1.2. Distribution of Genes Encoding Siderophore Receptors
3.1.3. Correlations Between Siderophore Production and Siderophore Receptor Gene Presence
3.2. Association Between Siderophores and Virulence-Associated Genes
3.2.1. Association with VAGs
3.2.2. Association with Phylogroups
3.2.3. Association with Bacteriocin Production
4. Discussion
5. Conclusions
Supplementary Materials
Author Contributions
Funding
Institutional Review Board Statement
Informed Consent Statement
Data Availability Statement
Acknowledgments
Conflicts of Interest
Abbreviations
| APEC | avian pathogenic Escherichia coli |
| CAS | chrome azurol S |
| ExPEC | extraintestinal pathogenic E. coli |
| FEC | fecal Escherichia coli |
| OFEC | organic fertilizers Escherichia coli |
| PAIs | pathogenicity islands |
| PCR | polymerase chain reaction |
| UPEC | uropathogenic Escherichia coli |
| UTI | urinary tract infection |
| UTIs | urinary tract infections |
| VAG | virulence-associated gene |
| VAGs | virulence-associated genes |
References
- Frawley, E.R.; Fang, F.C. The ins and outs of bacterial iron metabolism. Mol. Microbiol. 2014, 93, 609–616. [Google Scholar] [CrossRef]
- Andreini, C.; Bertini, I.; Cavallaro, G.; Holliday, G.L.; Thornton, J.M. Metal ions in biological catalysis: From enzyme databases to general principles. J. Biol. Inorg. Chem. 2008, 13, 1205–1218. [Google Scholar] [CrossRef]
- Fardeau, S.; Mullie, C.; Dassonville-Klimpt, A.; Audic, N.; Sonnet, P. Bacterial iron uptake: A promising solution against multidrug resistant bacteria. In Science Against Microbial Pathogens: Communicating Current Research and Technological Advances; Méndez-Vilas, A., Ed.; Microbiology book series number 3; Formatex Research Center: Badajoz, Spain, 2011; Volume 2, pp. 695–705. [Google Scholar]
- Ghssein, G.; Ezzeddine, Z. The Key Element Role of Metallophores in the Pathogenicity and Virulence of Staphylococcus aureus: A Review. Biology 2022, 11, 1525. [Google Scholar] [CrossRef]
- Mohsen, Y.; Tarchichi, N.; Barakat, R.; Kawtharani, I.; Ghandour, R.; Ezzeddine, Z.; Ghssein, G. The Different Types of Metallophores Produced by Salmonella enterica: A Review. Microbiol. Res. 2023, 14, 1457–1469. [Google Scholar] [CrossRef]
- Hider, R.C.; Kong, X. Chemistry and biology of siderophores. Nat. Prod. Rep. 2010, 27, 637–657. [Google Scholar] [CrossRef]
- Ratledge, C.; Dover, L.G. Iron metabolism in pathogenic bacteria. Annu. Rev. Microbiol. 2000, 54, 881–941. [Google Scholar] [CrossRef]
- Li, K.; Chen, W.H.; Bruner, S.D. Microbial siderophore-based iron assimilation and therapeutic applications. BioMetals 2016, 29, 377–388. [Google Scholar] [CrossRef] [PubMed]
- Torres, A.G.; Payne, S.M. Haem iron-transport system in enterohaemorrhagic Escherichia coli O157:H7. Mol. Microbiol. 1997, 23, 825–833. [Google Scholar] [CrossRef] [PubMed]
- Nagy, G.; Dobrindt, U.; Kupfer, M.; Emödy, L.; Karch, H.; Hacker, J. Expression of hemin receptor molecule ChuA is influenced by RfaH in uropathogenic Escherichia coli strain 536. Infect. Immun. 2001, 69, 1924–1928. [Google Scholar] [CrossRef]
- Lau, C.K.; Krewulak, K.D.; Vogel, H.J. Bacterial ferrous iron transport: The Feo system. FEMS Microbiol. Lett. 2016, 40, 273–298. [Google Scholar] [CrossRef] [PubMed]
- Cavas, L.; Kirkiz, I. Characterization of siderophores from Escherichia coli strains through genome mining tools: An antiSMASH study. AMB Express 2022, 12, 74. [Google Scholar] [CrossRef] [PubMed]
- Dozois, C.M.; Daigle, F.; Curtiss, R. Identification of pathogen-specific and conserved genes expressed in vivo by an avian pathogenic Escherichia coli strain. Proc. Natl. Acad. Sci. USA 2003, 100, 247–252. [Google Scholar] [CrossRef] [PubMed]
- Miethke, M.; Marahiel, M.A. Siderophore-based iron acquisition and pathogen control. Microbiol. Mol. Biol. Rev. 2007, 71, 413–451. [Google Scholar] [CrossRef] [PubMed]
- Khasheii, B.; Mahmoodi, P.; Mohammadzadeh, A. Siderophores: Importance in bacterial pathogenesis and applications in medicine and industry. Microbiol. Res. 2021, 250, 126790. [Google Scholar] [CrossRef]
- Fetherston, J.D.; Kirillina, O.; Bobrov, A.G.; Paulley, J.T.; Perry, R.D. The yersiniabactin transport system is critical for the pathogenesis of bubonic and pneumonic plague. Infect. Immun. 2010, 78, 2045–2052. [Google Scholar] [CrossRef] [PubMed]
- Azpiroz, M.F.; Laviña, M. Involvement of Enterobactin Synthesis Pathway in Production of Microcin H47. Antimicrob. Agents Chemother. 2004, 48, 1235–1241. [Google Scholar] [CrossRef] [PubMed]
- Thomas, X.; Destoumieux-Garzón, D.; Peduzzi, J.; Afonso, C.; Blond, A.; Birlirakis, N.; Goulard, C.; Dubost, L.; Thai, R.; Tabet, J.C.; et al. Siderophore peptide, a new type of post-translationally modified antibacterial peptide with potent activity. J. Biol. Chem. 2004, 279, 28233–28242. [Google Scholar] [CrossRef]
- Paauw, A.; Leverstein-van Hall, M.A.; van Kessel, K.P.; Verhoef, J.; Fluit, A.C. Yersiniabactin reduces the respiratory oxidative stress response of innate immune cells. PLoS ONE 2009, 4, e8240. [Google Scholar] [CrossRef] [PubMed]
- Holden, V.I.; Bachman, M.A. Diverging roles of bacterial siderophores during infection. Metallomics 2015, 7, 986–995. [Google Scholar] [CrossRef] [PubMed]
- Martin, P.; Tronnet, S.; Garcie, C.; Oswald, E. Interplay between siderophores and colibactin genotoxin in Escherichia coli. IUBMB Life 2017, 69, 435–441. [Google Scholar] [CrossRef]
- Vagarali, M.A.; Karadesai, S.G.; Patil, C.S.; Metgud, S.C.; Mutnal, M.B. Haemagglutination and siderophore production as the urovirulence markers of uropathogenic Escherichia coli. Indian J. Med. Microbiol. 2008, 26, 68–70. [Google Scholar] [CrossRef]
- Watts, R.E.; Totsika, M.; Challinor, V.L.; Mabbett, A.N.; Ulett, G.C.; De Voss, J.J.; Schembri, M.A. Contribution of siderophore systems to growth and urinary tract colonization of asymptomatic bacteriuria Escherichia coli. Infect. Immun. 2012, 80, 333–344. [Google Scholar] [CrossRef] [PubMed]
- Sonnenborn, U.; Schulze, J. The non-pathogenic Escherichia coli strain Nissle 1917—features of a versatile probiotic. Microb. Ecol. Health Dis. 2009, 21, 122–158. [Google Scholar] [CrossRef]
- Kuznetsova, M.V.; Provorova, S.V.; Kubarev, O.G.; Yudin, D.S.; Karimova, N.V.; Bajandina, N.V.; Teplyakova, M.A.; Demakov, V.A. Comparative characteristics of uropathogenic Escherichia coli strains, allocated in polyclinic and stationary conditions. Urologiia 2018, 6, 37–44. [Google Scholar] [CrossRef]
- Kuznetsova, M.V.; Gizatullina, J.S.; Nesterova, L.Y.; Starčič Erjavec, M. Escherichia coli isolated from cases of colibacillosis in Russian poultry farms (Perm Krai): Sensitivity to antibiotics and bacteriocins. Microorganisms 2020, 8, 741. [Google Scholar] [CrossRef] [PubMed]
- Mihailovskaya, V.S.; Remezovskaya, N.B.; Zhdanova, I.N.; Starčič Erjavec, M.; Kuznetsova, M.V. Virulence potential of faecal Escherichia coli strains isolated from healthy cows and calves on farms in Perm Krai. Vavilovskii Zhurnal Genet. I Sel. [Vavilov J. Genet. Breed.] 2022, 26, 486–494. [Google Scholar] [CrossRef]
- Heijnen, L.; Medema, G. Quantitative detection of E. coli, E. coli O:157 and other shiga toxin producing E. coli in water samples using a culture method combined with real-time PCR. J. Water Health 2006, 4, 487–498. [Google Scholar] [CrossRef]
- Alexander, D.B.; Zuberer, D.A. Use of chrome azurol S reagents to evaluate siderophore production by rhizosphere bacteria. Biol. Fertil. Soils 1991, 12, 39–45. [Google Scholar] [CrossRef]
- Searle, L.J.; Méric, G.; Porcelli, I.; Sheppard, S.K.; Lucchini, S. Variation in Siderophore Biosynthetic Gene Distribution and Production across Environmental and Faecal Populations of Escherichia coli. PLoS ONE 2015, 10, e0117906. [Google Scholar] [CrossRef] [PubMed]
- Johnson, J.R.; Stell, A.L. Extended Virulence Genotypes of Escherichia coli Strains from Patients with Urosepsis in Relation to Phylogeny and Host Compromise. J. Infect. Dis. 2000, 181, 261–272. [Google Scholar] [CrossRef]
- Nowrouzian, F.; Adlerberth, I.; Wold, A.E. P fimbriae, capsule and aerobactin characterize colonic resistant Escherichia coli. Epidemiol. Infect. 2000, 126, 11–18. [Google Scholar] [CrossRef] [PubMed][Green Version]
- Gordon, D.M.; O’Brien, C.L. Bacteriocin diversity and the frequency of multiple bacteriocin production in Escherichia coli. Microbiology 2006, 152, 3239–3244. [Google Scholar] [CrossRef]
- Clermont, O.; Christenson, J.K.; Denamur, E.; Gordon, D.M. The Clermont Escherichia coli phylo-typing method revisited: Improvement of specificity and detection of new phylo-groups. Environ. Microbiol. Rep. 2013, 5, 58–65. [Google Scholar] [CrossRef] [PubMed]
- Guiral, E.; Bosch, J.; Vila, J.; Soto, S.M. Prevalence of Escherichia coli among samples collected from the genital tract in pregnant and non-pregnant women: Relationship with virulence. FEMS Microbiol. Lett. 2011, 314, 170–173. [Google Scholar] [CrossRef]
- Chapman, T.A.; Wu, X.Y.; Barchia, I.; Bettelheim, K.A.; Driesen, S.; Trott, D.; Wilson, M.; Chin, J.J. Comparison of virulence gene profiles of Escherichia coli strains isolated from healthy and diarrheic swine. Appl. Environ. Microbiol. 2006, 72, 4782–4795. [Google Scholar] [CrossRef] [PubMed]
- Ulett, G.C.; Valle, J.; Beloin, C.; Sherlock, O.; Ghigo, J.M.; Schembri, M.A. Functional analysis of antigen 43 in uropathogenic Escherichia coli reveals a role in long-term persistence in the urinary tract. Infect. Immun. 2007, 75, 3233–3244. [Google Scholar] [CrossRef]
- Johnson, T.J.; Wannemuehler, Y.; Doetkott, C.; Johnson, S.J.; Rosenberger, S.C.; Nolan, L.K. Identification of minimal predictors of avian pathogenic Escherichia coli virulence for use as a rapid diagnostic tool. J. Clin. Microbiol. 2008, 46, 3987–3996. [Google Scholar] [CrossRef]
- Nakano, M.; Yamamoto, S.; Terai, A.; Ogawa, O.; Makino, S.; Hayashi, H.; Balakrish, N.G.; Kurazono, H. Structural and sequence diversity of the pathogenicity island of uropathogenic Escherichia coli which encodes the USP protein. FEMS Microbiol. Lett. 2001, 205, 71–76. [Google Scholar] [CrossRef]
- Kuhar, I.; Grabnar, M.; Žgur-Bertok, D. Virulence determinants of uropathogenic Escherichia coli in fecal strains from intestinal infections and healthy individuals. FEMS Microbiol. Lett. 1998, 164, 243–248. [Google Scholar] [CrossRef]
- Moulin-Schouleur, M.; Reperant, M.; Laurent, S.; Bree, A.; Mignon-Grasteau, S.; Germon, P.; Rasschaert, D.; Schouler, C. Extraintestinal pathogenic Escherichia coli strains of avian and human origin: Link between phylogenetic relationships and common virulence patterns. J. Clin. Microbiol. 2007, 45, 3366–3376. [Google Scholar] [CrossRef]
- Kerényi, M.; Allison, H.E.; Bátai, I.; Sonnevend, A.; Emödy, L.; Plaveczky, N.; Pál, T. Occurrence of hlyA and sheA genes in extraintestinal Escherichia coli strains. J. Clin. Microbiol. 2005, 43, 2965–2968. [Google Scholar] [CrossRef]
- Lescat, M.; Clermont, O.; Woerther, P.L.; Glodt, J.; Dion, S.; Skurnik, D. Commensal Escherichia coli strains in Guiana reveal a high genetic diversity with hostdependant population structure. Environ. Microbiol. Rep. 2012, 5, 49–57. [Google Scholar] [CrossRef]
- Pugsley, A.P. Escherichia coli K12 strains for use in the identification and characterization of colicins. J. Gen. Microbiol. 1985, 131, 369–376. [Google Scholar] [CrossRef]
- Spurbeck, R.R.; Dinh, P.C., Jr.; Walk, S.T.; Stapleton, A.E.; Hooton, T.M.; Nolan, L.K.; Kim, K.S.; Johnson, J.R.; Mobley, H.L. Escherichia coli isolates that carry vat, fyuA, chuA, and yfcV efficiently colonize the urinary tract. Infect. Immun. 2012, 80, 4115–4122. [Google Scholar] [CrossRef]
- Kumar, G.; Kumar, Y.; Kumar, G.; Tahlan, A. Selection and characterization of siderophores of pathogenic Escherichia coli intestinal and extraintestinal isolates. Open Agric. 2021, 6, 456–465. [Google Scholar] [CrossRef]
- Feldmann, F.; Sorsa, L.J.; Hildinger, K.; Schubert, S. The Salmochelin Siderophore Receptor IroN Contributes to Invasion of Urothelial Cells by Extraintestinal Pathogenic Escherichia coli in vitro. Infect. Immun. 2007, 75, 3183–3187. [Google Scholar] [CrossRef]
- Khazaal, M.T.; El-Hendawy, H.H.; Mabrouk, M.I.; I Faraag, A.H.; Bakkar, M.R. Antibiotic resistance and siderophores production by clinical Escherichia coli. BioTechnologia 2022, 103, 169–184. [Google Scholar] [CrossRef]
- Khasheii, B.; Anvari, S.; Jamalli, A. Frequency evaluation of genes encoding siderophores and the effects of different concentrations of Fe ions on growth rate of uropathogenic Escherichia coli. Iran. J. Microbiol. 2016, 8, 359–365. [Google Scholar] [PubMed]
- Karimian, A.; Momtaz, H.; Mahbobe Madani, M. Detection of Uropathogenic Escherichia coli virulence factors in patients with urinary tract infections in Iran. Afr. J. Microbiol. Res. 2012, 6, 6811–6816. [Google Scholar] [CrossRef]
- Al-Zerfi, H.S.; Al-Hilu, S.A. Investigation of Genes Encoding Siderophores in Escherichia coli Isolated from Cystitis Patients. BIO Web Conf. 2024, 108, 04006. [Google Scholar] [CrossRef]
- Nateghi, F.; Jafarpour, M.; Nazemi, A. A Survey for Detection of Eight Correlated Genes of Avian Pathogenic E coli in Human Uropathogenic Escherichia coli. J. Microb. World 2010, 3, 169–176. [Google Scholar]
- Makarova, M.A.; Matveeva, Z.N.; Kaftyreva, L.A. Extended-spectrum cephalosporin resistance of diarrheagenic Escherichia coli strains. Probl. Med. Mycol. 2020, 22, 101. [Google Scholar] [CrossRef]
- Gao, Q.; Wang, X.; Xu, H.; Xu, Y.; Ling, J.; Zhang, D.; Gao, S.; Liu, X. Roles of iron acquisition systems in virulence of extraintestinal pathogenic Escherichia coli: Salmochelin and aerobactin contribute more to virulence than heme in a chicken infection model. BMC Microbiol. 2012, 12, 143. [Google Scholar] [CrossRef] [PubMed]
- Ons, E.; Bleyen, N.; Tuntufye, H.N.; Vandemaele, F.; Goddeeris, B.M. High prevalence iron receptor genes of avian pathogenic Escherichia coli. Avian Pathol. 2007, 36, 411–414. [Google Scholar] [CrossRef] [PubMed][Green Version]
- Caza, M.; Lépine, F.; Milot, S.; Dozois, C.M. Specific roles of the iroBCDEN genes in virulence of an avian pathogenic Escherichia coli O78 strain and in production of salmochelins. Infect. Immun. 2008, 76, 3539–3549. [Google Scholar] [CrossRef]
- Apostolakos, I.; Laconi, A.; Mughini-Gras, L.; Yapicier, Ö.Ş.; Piccirillo, A. Occurrence of Colibacillosis in Broilers and Its Relationship With Avian Pathogenic Escherichia coli (APEC) Population Structure and Molecular Characteristics. Front. Vet. Sci. 2021, 8, 737720. [Google Scholar] [CrossRef]
- Sabaté, M.; Moreno, E.; Pérez, T.; Andreu, A.; Prats, G. Pathogenicity island markers in commensal and uropathogenic Escherichia coli isolates. Eur. J. Clin. Microbiol. Infect. Dis. 2006, 12, 880–886. [Google Scholar] [CrossRef] [PubMed]
- Samei, A.; Haghi, F.; Zeighami, H. Distribution of pathogenicity island markers in commensal and uropathogenic Escherichia coli isolates. Folia Microbiol. 2016, 61, 261–268. [Google Scholar] [CrossRef]
- Rezatofighi, S.E.; Mirzarazi, M.; Salehi, M. Virulence genes and phylogenetic groups of uropathogenic Escherichia coli isolates from patients with urinary tract infection and uninfected control subjects: A case-control study. BMC Infect. Dis. 2021, 21, 361. [Google Scholar] [CrossRef] [PubMed]
- Ochoa, S.A.; Cruz-Córdova, A.; Luna-Pineda, V.M.; Reyes-Grajeda, J.P.; Cázares-Domínguez, V.; Escalona, G.; Sepúlveda-González, M.E.; López-Montiel, F.; Arellano-Galindo, J.; López-Martínez, B. Multidrug- and Extensively Drug-Resistant Uropathogenic Escherichia coli Clinical Strains: Phylogenetic Groups Widely Associated with Integrons Maintain High Genetic Diversity. Front. Microbiol. 2016, 7, 2042. [Google Scholar] [CrossRef] [PubMed]
- Mazurek-Popczyk, J.; Pisarska, J.; Bok, E.; Baldy-Chudzik, K. Antibacterial activity of bacteriocinogenic commensal Escherichia coli against zoonotic strains resistant and sensitive to antibiotics. Antibiotics 2020, 9, 411. [Google Scholar] [CrossRef]
- Bosák, J.; Hrala, M.; Micenková, L.; Šmajs, D. Non-antibiotic antibacterial peptides and proteins of Escherichia coli: Efficacy and potency of bacteriocins. Expert Rev. Anti-Infect. Ther. 2021, 19, 309–322. [Google Scholar] [CrossRef]
- Massip, C.; Oswald, E. Siderophore-Microcins in Escherichia coli: Determinants of Digestive Colonization, the First Step Toward Virulence. Front. Cell. Infect. Microbiol. 2020, 10, 381. [Google Scholar] [CrossRef] [PubMed]
- da Rocha, A.C.; da Silva, A.B.; de Brito, A.B.; Moraes, H.L.; Pontes, A.P.; Cé, M.C.; do Nascimento, V.P.; Salle, C.T. Virulence factors of avian pathogenic Escherichia coli isolated from broilers from the south of Brazil. Avian Dis. 2002, 46, 749–753. [Google Scholar] [CrossRef]
- Ezzeddine, Z.; Ghssein, G. Towards new antibiotics classes targeting bacterial metallophores. Microb. Pathog. 2023, 182, 106221. [Google Scholar] [CrossRef]
- Nair, A.; Juwarkar, A.A.; Singh, S.K. Production and characterization of siderophores and its application in arsenic removal from contaminated soil. Water Air Soil Pollut. 2007, 180, 199–212. [Google Scholar] [CrossRef]
- Ezzeddine, Z.; Ghssein, G. Metallophores as promising chelates for heavy metals removal from polluted water. Bioremediation J. 2024, 1–3. [Google Scholar] [CrossRef]

| Gene | Nucleotide Sequence (5′→3′) | Program | Amplicon Size (bp) | Reference |
|---|---|---|---|---|
| fepA | TTTGTCGAGGTTGCCATACA CACGCTGATTTTGATTGACG | 95 °C, 3 min; 35 × [95 °C, 2 min; 55 °C, 30 s; 72 °C, 1 min]; 72 °C, 1 min | 349 | [30] |
| fyuA | GGGAATGTGAAACTGCGTCT CGGGTGCCAAGTTCATAGTT | 791 | ||
| iroN | AAGTCAAAGCAGGGGTTCGGGC GACGCCGACCATTAAGACGCAG | 94 °C, 2.5 min; 25 × [94 °C, 30 s; 64 °C, 30 s; 72 °C, 2 min] 72 °C, 10 min | 648 | [31] |
| iutA | GGCTGGACATCATGGGAACTGG CGTCGGGAACGGGTAGAATCG | 94 °C, 4 min; 25 × [94 °C, 2 min; 65 °C, 1 min; 72 °C, 30 s] 72 °C, 10 min | 301 | [32] |
| mccH47 | CACTTTCATCCCTTCGGATTG AGCTGAAGTCGCTGGCGCACCTCC | 95 °C, 12 min; 25 × [94 °C, 30 s; 55 °C, 30 s; 68 °C, 30 s]; 72 °C, 3 min | 227 | [33] |
| mccM | CGTTTATTATTTTATGCATA AAACGGAAGAATGGATGATCTCGCAAA | 456 |
| Protein | Gene | Prevalence of Siderophore Receptor Genes in E. coli Groups (%) | ||||
|---|---|---|---|---|---|---|
| Human UPEC (n = 26) | APEC (n = 28) | Avian OFEC (n = 19) | Cattle FEC (n = 49) | Cattle OFEC (n = 35) | ||
| Salmochelin receptor | iroN | 23.1 | 67.9 | 68.4 | 22.4 | 5.7 |
| Ferric aerobactin receptor | iutA | 61.5 | 42.9 | 42.1 | 26.5 | 2.9 |
| Yersiniabactin receptor | fyuA | 69.2 | 28.6 | 31.6 | 28.6 | 25.7 |
| Ferric enterobactin receptor | fepA | 100 | 89.3 | 100 | 95.9 | 94.3 |
| Gene/Property | Prevalence in E. coli Groups (%) | ||||
|---|---|---|---|---|---|
| Human UPEC (n = 26) | APEC (n = 28) | Avian OFEC (n = 19) | Cattle FEC (n = 49) | Cattle OFEC (n = 35) | |
| mccM | 15.4 | 3.6 | 21.0 | 20.5 | 0 |
| mccH47 | 7.7 | 0 | 10.5 | 4.1 | 0 |
| Bacteriocin production | 19.2 | 71.4 | 89.5 | 26.5 | 14.3 |
Disclaimer/Publisher’s Note: The statements, opinions and data contained in all publications are solely those of the individual author(s) and contributor(s) and not of MDPI and/or the editor(s). MDPI and/or the editor(s) disclaim responsibility for any injury to people or property resulting from any ideas, methods, instructions or products referred to in the content. |
© 2025 by the authors. Licensee MDPI, Basel, Switzerland. This article is an open access article distributed under the terms and conditions of the Creative Commons Attribution (CC BY) license (https://creativecommons.org/licenses/by/4.0/).
Share and Cite
Kuznetsova, M.V.; Mihailovskaya, V.S.; Selivanova, P.A.; Kochergina, D.A.; Remezovskaya, N.B.; Starčič Erjavec, M. Siderophore Production, Diversity of Siderophore Receptors and Associations with Virulence-Associated Genes, Phylogroups and Bacteriocin Production in Escherichia coli Strains Isolated from Humans, Animals and Organic Fertilizers. Microbiol. Res. 2025, 16, 50. https://doi.org/10.3390/microbiolres16020050
Kuznetsova MV, Mihailovskaya VS, Selivanova PA, Kochergina DA, Remezovskaya NB, Starčič Erjavec M. Siderophore Production, Diversity of Siderophore Receptors and Associations with Virulence-Associated Genes, Phylogroups and Bacteriocin Production in Escherichia coli Strains Isolated from Humans, Animals and Organic Fertilizers. Microbiology Research. 2025; 16(2):50. https://doi.org/10.3390/microbiolres16020050
Chicago/Turabian StyleKuznetsova, Marina V., Veronika S. Mihailovskaya, Polina A. Selivanova, Darja A. Kochergina, Natalia B. Remezovskaya, and Marjanca Starčič Erjavec. 2025. "Siderophore Production, Diversity of Siderophore Receptors and Associations with Virulence-Associated Genes, Phylogroups and Bacteriocin Production in Escherichia coli Strains Isolated from Humans, Animals and Organic Fertilizers" Microbiology Research 16, no. 2: 50. https://doi.org/10.3390/microbiolres16020050
APA StyleKuznetsova, M. V., Mihailovskaya, V. S., Selivanova, P. A., Kochergina, D. A., Remezovskaya, N. B., & Starčič Erjavec, M. (2025). Siderophore Production, Diversity of Siderophore Receptors and Associations with Virulence-Associated Genes, Phylogroups and Bacteriocin Production in Escherichia coli Strains Isolated from Humans, Animals and Organic Fertilizers. Microbiology Research, 16(2), 50. https://doi.org/10.3390/microbiolres16020050

